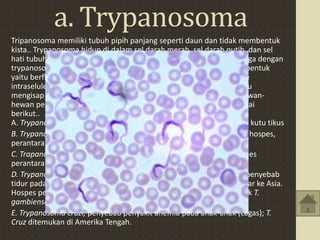
a. Trypanosoma
Tripanosoma memiliki tubuh pipih panjang seperti daun dan tidak membentuk
kista.. Trypanosoma hidup di dalam sel darah merah, sel darah putih, dan sel
hati tubuh vertebrata inagnya. Infeksi karena Trypanosoma disebut juga dengan
trypanosomiasis. Dalam siklus hidupnya, Trypanosoma memiliki dua bentuk
yaitu berflagela pada fase ekstraseluler dan tidak berflagela pada fase
intraseluler. Sebagian dari siklus hidupnya melekat di sel lambung atau
mengisap darah manusia. Hospes per-antara Trypanosoma adalah hewan-
hewan pengisap darah. Contoh jenis-jenis Trypanosoma adalah sebagai
berikut..
A. Trypanosoma lewisi, hidup pada tikus, hospes perantaranya adalah kutu tikus
B. Trypanosoma evansi, penyebab penyakit sura (malas) pada ternak, hospes,
perantaranya adalah lalat tabanus.
C. Trapanosoma brucei, penyebab penyakit nagano pada ternak, hospes
perantaranya adalah lalat tse-tse
D. Trypanosoma gambiense dan Trypanosoma rhodensiense. Hewan penyebab
tidur pada manusia ini mulanya terdapat di Afrika, kemudian menyebar ke Asia.
Hospes perantaranya adalah lalat tse-tse, yaitu Glossina palpalis untuk T.
gambiense dan Glossina mursitans untuk T. rhodesiense.
E. Trypanosoma cruzi, penyebab penyakit anemia pada anak-anak (cagas); T.
Cruz ditemukan di Amerika Tengah.

Flagellata adalah kelompok protista yang memiliki satu atau lebih flagela untuk bergerak dan berenang. Terdiri dari fitoflagellata, zooflagellata, euglenoida, dinoflagellata, dan volvocida. Beberapa contoh genus parasit yang berbahaya bagi manusia adalah Trypanosoma dan Leishmania.